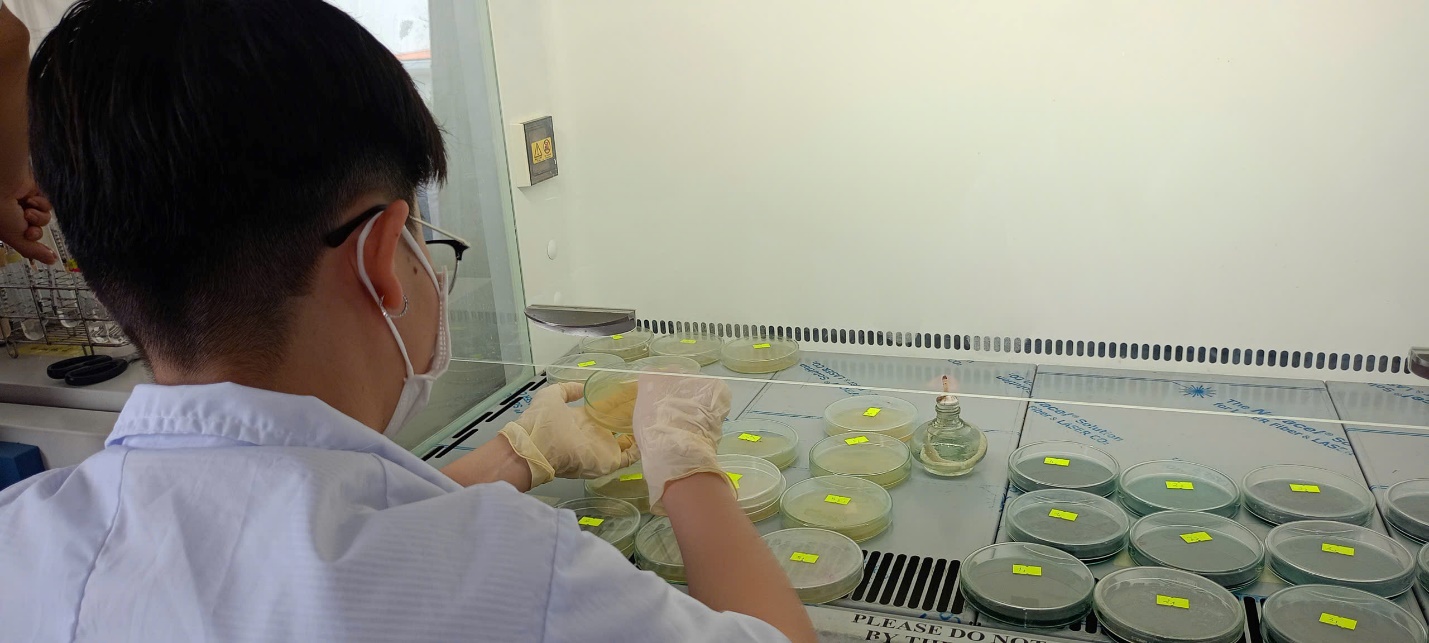

Nhằm tăng cường gắn kết giữa lý thuyết và thực tiễn đối với ngành Khoa học môi trường và chuyên ngành Bảo vệ môi trường thủy sản, Khoa Nông nghiệp và Thủy sản đã tổ chức chuyến thực tập giáo trình cơ sở cho sinh viên lớp 18DKHMT và lớp 17DBVMTTS với nhiều hoạt động chuyên môn thiết thực. Học phần được tổ chức thành 02 phần chính: Khảo sát thực địa và Thực hành phân tích mẫu trong phòng thí nghiệm nhằm giúp sinh viên củng cố kiến thức nền tảng và phát triển kỹ năng nghề nghiệp cần thiết.
Phần 1: Tham quan, khảo sát và thu thập mẫu ngoài thực địa
Trong phần tham quan thực tế, sinh viên đã đến khảo sát tại các địa điểm tiêu biểu của khu vực Đồng bằng sông Cửu Long gồm: Rừng tràm Trà Sư (An Giang), Vườn quốc gia Tràm Chim (Đồng Tháp). Tại mỗi điểm đến, sinh viên được giảng viên hướng dẫn quan sát hệ sinh thái đặc trưng, tìm hiểu đa dạng sinh học, đặc điểm thảm thực vật và hiện trạng môi trường nước - đất.
Bên cạnh hoạt động tham quan, sinh viên trực tiếp thực hành các kỹ năng lấy mẫu nước và đất theo đúng quy trình khoa học. Các nhóm tiến hành xác định vị trí lấy mẫu, ghi chép thông tin hiện trường, thực hành lấy mẫu và bảo quản mẫu đúng kỹ thuật trước khi vận chuyển về phòng thí nghiệm. Thông qua hoạt động này, sinh viên không chỉ nâng cao kỹ năng thực địa mà còn nhận thức rõ hơn về vai trò của việc bảo tồn hệ sinh thái rừng ngập nước và quản lý tài nguyên thiên nhiên bền vững.
Phần 2: Thực hành phân tích mẫu trong phòng thí nghiệm
Sau chuyến khảo sát tại Đồng Tháp và An Giang, sinh viên tiếp tục lấy mẫu ở một số nơi trên địa bàn tỉnh Cà Mau và tiến hành giai đoạn thực hành trong phòng thí nghiệm với nội dung phân tích các chỉ tiêu cơ bản của mẫu nước và đất đã thu thập. Dưới sự hướng dẫn của giảng viên, sinh viên được thực hành quy trình chuẩn bị mẫu, sử dụng các thiết bị phân tích và tiến hành đo các thông số của mẫu nước như pH, độ mặn, TDS, TSS, BOD, COD, DO, Fe2+; xác định mật số vi sinh vật dị dưỡng trong nước và đất; nhận diện và đếm mật số chủng vi khuẩn gây bệnh trên tôm.
Ngoài việc thao tác kỹ thuật, sinh viên còn được hướng dẫn cách xử lý số liệu, đánh giá kết quả và liên hệ với điều kiện môi trường thực tế tại khu vực lấy mẫu. Hoạt động này góp phần giúp sinh viên hiểu rõ hơn mối quan hệ giữa số liệu phân tích và hiện trạng môi trường, đồng thời hình thành tư duy khoa học và khả năng làm việc nhóm trong nghiên cứu.
Học phần Thực tập giáo trình cơ sở đã mang lại nhiều trải nghiệm bổ ích đối với sinh viên ngành Khoa học môi trường và chuyên ngành Bảo vệ môi trường thủy sản tại Khoa Nông nghiệp và Thủy sản, Trường Đại học Bạc Liêu. Thông qua chuyến thực tập giáo trình ngoài thực địa kết hợp phân tích mẫu vật trong phòng thí nghiệm, sinh viên hệ thống kiến thức chuyên môn, rèn luyện kỹ năng thực hành và nâng cao ý thức bảo vệ môi trường. Đây là nền tảng quan trọng để sinh viên ngành Khoa học môi trường và chuyên ngành Bảo vệ môi trường thủy sản chuẩn bị cho các học phần chuyên sâu và định hướng nghề nghiệp trong tương lai.
Một số hình ảnh trong chuyến thực tập:

Tin và ảnh: Trần Ngọc Hạnh

